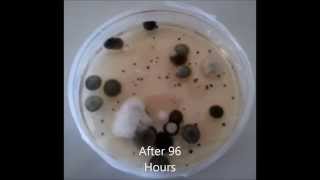
Medicare.gov - Is your Nursing Home clean? Having a "Five Star" rating doen't mean it's clean.

Song info
"When You Get Home" Videos
Lyrics
I miss you, baby
Come on home
Yeah, yeah
Oooh, oooh, oooh
Sun rising, a new day brings
Thoughts of you
Good memories, of the joy you bring
And all that you do
As I go on through with my day I
I fantasies about you in my life
And even though we talk on the phone
Its not like being with you, no
Cause wrapped in your arms is where I belong
Ill be waiting when you get home
The days almost done
And night times begun
Ill be waiting when you get home, yeah
I cant wait, to feel your arms
In warm embrace
Search my soul
And feel with your love
So boy I can taste it
Im so happy that youre in my life
To keep you all and though sacrifice
And all those times I spent alone
Leaves me longing for you, oh oh oh ooh
(wrapped in your arms) ooh baby (is where I belong) yeah
(Ill be waiting when you get home)
Ooh you know Ill be there
(The days almost done) days almost done
(And night times begun) night times begun
(Ill be waiting when you get home) baby yeah, ooh
(when you get home) ooh, ooh
I love you, ooh ooh I baby
As I go on through with my day I
I fantasies about you in my life
And even though we talk on the phone
Its not like being with you, no, nnno
(wrapped in your arms is where I belong) yeah
(Ill be waiting when you get home)
Ooh you know Ill be there
(The days almost done) days almost done
(And night times begun)
Ill be waiting when you get home
(Ill be waiting when you get home) ooh yeah
(wrapped in your arms) dont you stay away too long
(is where I belong)
(Ill be waiting) yeah (when you get home)
(The days almost done) days almost done
(And night times begun) night times begun
(Ill be waiting when you get home)
(wrapped in your arms)
- 0 Bản dịch
Hiện tại chưa có lời dịch cho bài hát này. Bạn hãy là người đầu tiên chia sẻ lời dịch cho bài hát này nhé !
Đăng lời dịchAlbums has song "When You Get Home"

Singles
53 songs
- Rain Or Shine 2008
- System Addict 2013
- Can't Wait Another Minute 2012
- Let Me Be The One 2013
- Stay Out Of My Life 2013
- All Fall Down 2008
- Strong As Steel 2008
- The Slightest Touch 2013
- Treat Me Like A Lady 2013
- Something About My Baby 2013
- Find The Time 2008
- If I Say Yes (extended Version) 2013
- Say Goodbye 2013
- Secret From My Heart 2013
- Feel Much Better 2013
- Love Take Over 2013
- Somewhere, Somebody 2013
- With Every Heartbeat 2013
- That's The Way I Like It 2013
- The Best Of Me 2013
- Whenever You're Ready 2008
- There's A Brand New World 2013
- When You Get Home 2013
- Hide And Seek 2013
- Save A Place (in Your Heart For Me) 2013
- I'm Still Waiting 2013
- Rock My World 2012
- What About Me Baby 2013
- Love Games 2013
- Going With The Moment 2013
- One Way Mirror 2013
- Live Giving Love 2013
- Feelings 2013
- Read Between The Lines 2013
- Hot Love 2012
- The Writing On The Wall 2013
- Surely (remix) 2013
- It 2013
- Crazy 2013
- Are You Really The One 2013
- I Give You Give 2013
- Hung Up 2013
- Winning 2013
- Hard Race 2013
- Someone's In Love (radio Remix) 2013
- Funktafied 2013
- Free Time 2013
- Got A Lot Of Love 2013
- (i Love You) For Sentimental Reasons 2013
- Get A Life Together 2013
- R.s.v.p. 2013
- Now I'm In Control 2013
- Lost In You 2013

Singles
53 songs
- Rain Or Shine 2008
- System Addict 2013
- Can't Wait Another Minute 2012
- Let Me Be The One 2013
- Stay Out Of My Life 2013
- All Fall Down 2008
- Strong As Steel 2008
- The Slightest Touch 2013
- Treat Me Like A Lady 2013
- Something About My Baby 2013
- Find The Time 2008
- If I Say Yes (extended Version) 2013
- Say Goodbye 2013
- Secret From My Heart 2013
- Feel Much Better 2013
- Love Take Over 2013
- Somewhere, Somebody 2013
- With Every Heartbeat 2013
- That's The Way I Like It 2013
- The Best Of Me 2013
- Whenever You're Ready 2008
- There's A Brand New World 2013
- When You Get Home 2013
- Hide And Seek 2013
- Save A Place (in Your Heart For Me) 2013
- I'm Still Waiting 2013
- Rock My World 2012
- What About Me Baby 2013
- Love Games 2013
- Going With The Moment 2013
- One Way Mirror 2013
- Live Giving Love 2013
- Feelings 2013
- Read Between The Lines 2013
- Hot Love 2012
- The Writing On The Wall 2013
- Surely (remix) 2013
- It 2013
- Crazy 2013
- Are You Really The One 2013
- I Give You Give 2013
- Hung Up 2013
- Winning 2013
- Hard Race 2013
- Someone's In Love (radio Remix) 2013
- Funktafied 2013
- Free Time 2013
- Got A Lot Of Love 2013
- (i Love You) For Sentimental Reasons 2013
- Get A Life Together 2013
- R.s.v.p. 2013
- Now I'm In Control 2013
- Lost In You 2013

Recent comments